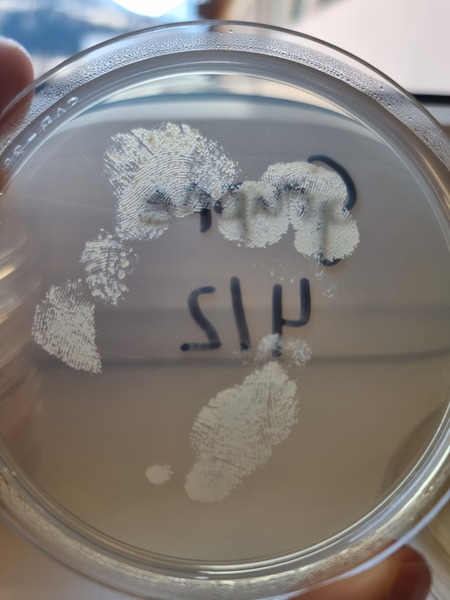
20250307 131946
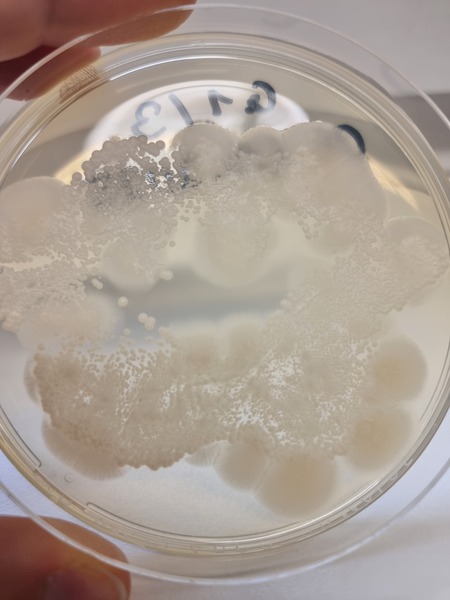
20250310 082828
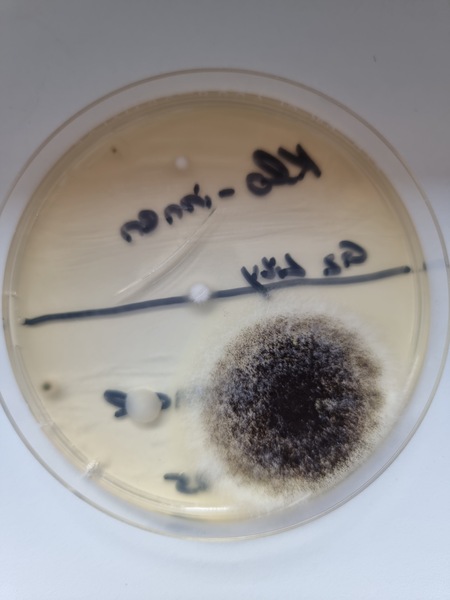
20250313 140635
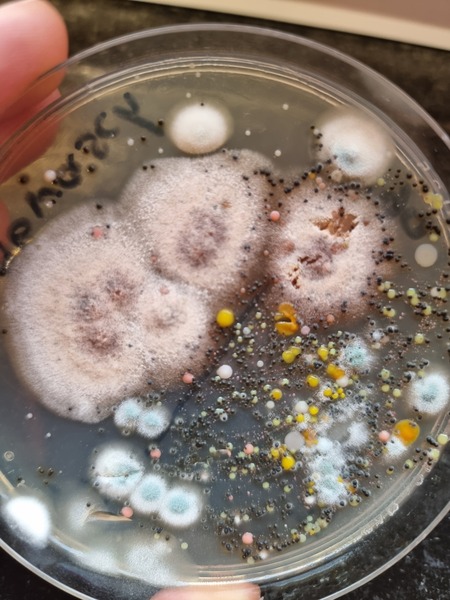
20250314 131710

Archiv 2024/25
Projekt: Bakterien wachsen
Im Biologieunterricht wurde beobachtet, wie viele Bakterien mittels „Handshake“ weitergegeben werden.
4c 2024/25






Im Biologieunterricht wurde beobachtet, wie viele Bakterien mittels „Handshake“ weitergegeben werden.
4c 2024/25